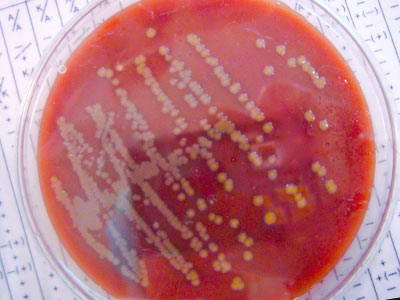
Biomedical science students gain hands-on lab experience

Biomedical Sciences
You’ll explore course work specific to the biomedical field, gain knowledge and experience through internships and have the cognitive course work to promote success on entrance examinations to graduate programs. With a degree in biomedical sciences, you’ll be able to successfully pursue a variety of careers.
Career Potential with a bachelors in bio medical studies
- Chiropractor
- Dentist
- Doctor of osteopathic medicine
- Medical imaging technician
- Optometrist
- Physician assistant
- Physical therapist
- Physician
- Veterinarian
Internships and Research opportunities as a bio med major
You’ll engage in internship and job shadowing experiences that contribute to credentials for medical program applications. Opportunities are available with:
- Chiropractors
- Hospitals
- Pathology laboratory
- Physicians
- Physical therapists
- Veterinarians
The employment opportunities in this feed are a sample from Career Services’ Handshake portal. Some positions may require additional certifications. Handshake is available to current SUNY Cortland students and alumni.
Special Features: research and hands-on experience
- Faculty dedicated to providing quality education and research opportunities include:
- Christa Chatfield, microbiology and biofilm development of Legionella
- Patricia Conklin, molecular genetic of vitamin C pathways in Arabidopsis
- Theresa Curtis, mammalian wound healing responses
- Louis Gatto, histology and pulmonary science
- Christian Nelson, cell biology and virology
- John Straneva, pathology and parasitology
- If you participate in a research project, you may find yourself presenting your scientific findings at local and regional professional meetings.
- Study and work in our state-of-the-art classroom and research facility.
Get Involved
College is more than a classroom. Enhance your experience with extracurricular opportunities.
Student Clubs
Honor Societies
Beta Beta Beta, National Biological Honor Society